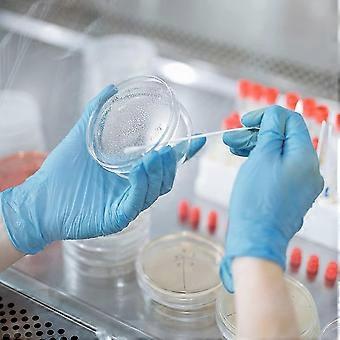
product image

120 Pack Sterile Plastic With Lid, 90 X 15 Mm Sterile Dish Clear Lab Cell Culture Dishes
+ ٧٨٢٫٤٩ E£ الشحن
120 Pack Sterile Plastic With Lid, 90 X 15 Mm Sterile Dish Clear Lab Cell Culture Dishes
- العلامة التجارية: Unbranded

120 Pack Sterile Plastic With Lid, 90 X 15 Mm Sterile Dish Clear Lab Cell Culture Dishes
- العلامة التجارية: Unbranded
| سعر البيع القطاعي المقترح: | |
| السعر: | |
| أنت توفر: | ٤٬٠٩١٫٠٠ E£ (49%) |
في المخزون
سياسة الإرجاع لمدة 14 يوما
نقبل وسائل الدفع الآتية
الوصف
120 Pack Sterile Plastic With Lid, 90 X 15 Mm Sterile Dish Clear Lab Cell Culture Dishes
- العلامة التجارية: Unbranded
- الفئة: أطباق بتري
- هوية Fruugo: 251915798-545503365
- EAN: 8130980292224
التسليم والرد
يُرسل خلال ٢ أيام
-
STANDARD: ٧٨٢٫٤٩ E£ - التسليم بين الاثنين 29 ديسمبر 2025 – الثلاثاء 13 يناير 2026
يُشحن من الصين.
نحن نبذل قصارى جهدنا لضمان أن تصلك المنتجات التي تطلبها بالكامل وطبقاً المواصفات التي حددتها. إلا أنه في حال تلقيك طلب غير كامل أو أغراض تختلف عن تلك التي طلبتها أو كان هناك سبب آخر يدعوك لعدم الرضاء عن الطلب، فيمكنك رد الطلب أو أي منتجات يتضمنها الطلب واسترداد ما دفعته من أجل تلك الأغراض بالكامل. عرض سياسة الرد الكاملة